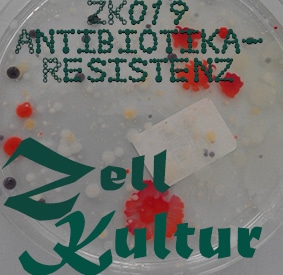

Corona-Fake-News sind derzeit überall. Und besserwisserisch wie wir sind, möchten wir unwissenschaftlichen Mumpitz nicht unkommentiert lassen. Damit bekommt auch ihr eine Argumentationsgrundlage an die Hand, falls mal wieder jemand versucht quer zu denken, bevor er gerade denken gelernt hat. Daher haben wir keine Kosten und Mühen gescheut, ein paar populäre Coronamythen zu entzaubern. Pünktlich zu Halloween wollen wir diese Geister austreiben!
Dazu sprechen wir über “Schrödingers Maske”, deren Poren gleichzeitig groß genug für Viruspartikel aber zu klein für Sauerstoff- und Kohlenstoffdioxid-Moleküle sind, ob es sinnvoll ist, dass Immunsystem zu stärken (Schlaf ist dafür gut. Schlaf ist immer gut!) und Aussagekraft, Spezifität und Sensitivität des Sars-CoV-2-PCR-Tests. Wir klären die Frage, ob Kary Mullis, der Erfinder des PCR-Tests dessen Anwendung zum Nachweis von Viren ablehnt. Jedenfalls hat er einen eigenen Song.
Es macht übrigens keinen Unterschied, ob wir nur „Schnipsel“ des Virus finden – es ist das selbe Prinzip wie bei der Forensik. Sind die Schnipsel der RNA vorhanden, dann war der Mörder der Gärtner – oder wie war das nochmal? Jedenfalls brauchen wir nicht für jeden Corona-Test gleich das ganze Viren-Genom zu sequenzieren, schließlich würde das viel länger dauern und ihr müsstest noch länger auf euer Testergebnis warten.
Außerdem werden wieder die sogenannten “Koch’schen Postulate” (eigentlich Henle-Koch-Postulate) als Argument aufgegriffen, obwohl schon ein anderer Virusleugner mit der Ausschreibung eines Preisgelds für den Nachweis von Masernviren baden ging. Diese Postulate gehen übrigens zurück auf den Namensgebers des RKI: den deutschen Arzt und Mikrobiologen Robert Koch.
Übrigens ist es erstaunlich, dass immer noch viele den Unterschied zwischen einer saisonalen Erkrankung wie der jährlichen Grippe und einer Pandemie nicht kennen und so die Gefährlichkeit falsch einordnen.
In der Biofrage geht es darum, ob Dr. Fauci in einer wissenschaftlichen Publikation Todesfälle durch die Spanische Grippe 1918 mit dem Tragen von Masken in Verbindung gebracht hat.
Der Pestarzt, der sich auf unser Cover verirrt hat, ist übrigens Mike Beckers, dessen Foto wir dankenswerter Weise verwenden durften. Laut unserem Haus-und-Hof-Archäologen gab es diese Pestarztmasken jedoch nicht zu Zeiten der Pest.
Wenn euch die Folge gefallen hat, werft uns doch via Paypal ein paar Groschen in den Hut. 😉 Oder schreibt unserem Podcast eine Bewertung auf iTunes, Spotify oder anderen Podcastportalen.